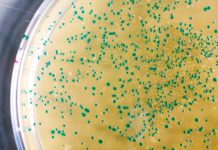

Instagram вводит новую функцию Restrict для защиты от хулиганов
Социальная сеть Instagram продолжает демонстрировать необычайную гибкость в отношении развития своей платформы – сегодня стало известно о том, что руководство социальн...
НАСА отыскала «ингредиенты жизни» на спутнике Сатурна
Сегодня ответственная команда исследователей из американского космического агентства НАСА представила результаты своего нового исследования, связанного с обнаружением ...
Исследования показали наличие новых соединений в вейпах
Новое исследование в отношении выяснения реальной степени угрозы вейпа и вейп-продуктов сегодня было представлено в рамках нового проекта команды медицинских специалис...
Google тестирует транскрибирование в приложении Recorder
Последние четыре дня на нас навалился целый шквал новой информации касательно грядущего флагмана корпорации Google - Pixel 4. И вот, новая информация гласит, что с выхо...
Intel представила новые процессоры и снизила цены на старые
Рынок центральных процессоров для персональных компьютеров представлен исключительно двумя техническими гигантами - AMD и Intel. Невозможно сказать кто именно из них лу...
Туберкулез может быть окончательно побежден новым соединением
Туберкулез является одним из наиболее заразных заболеваний в мире, организуемых при помощи соответствующих бактерий семейства Mycobacterium tuberculosis – таким образо...
Специалисты тестируют новый генератор, работающий на морской воде
Сегодня специалистами из Восточно-Китайского Университета был представлен новый уникальный метод создания и улучшения подводных генераторов энергии, которые могли бы п...
Ученые работают над необычным пакетом молока с QR-кодом
Пищевая промышленность на данный момент переживает самый настоящий пик технологической революции, которая выражается в самом широком комплексе аспектов – начиная от пр...
Представлен необычный домик на дереве Blue Forest Treehouse
Довольно необычный архитектурный проект сегодня был представлен специалистами компании Blue Forest – проект носит название Blue Forest Treehouse и представляет собой о...
Создан уникальный мозговой имплант для нейронных сигналов
Возможность мозга управлять нашим телом уже никого не удивляет – однако возможность управлять мозгом с этой целью представляется концептуальной иной задачей, несоизмер...